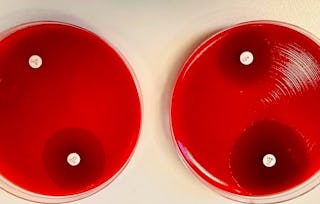

Instructors

The Pennsylvania State University

Rice University

University of Michigan

University of Michigan
Pharmacy Instructors Courses
You can use your AIU admin account to add the course you need to try out and then switch to your learner account to enroll.
Technical University of Denmark (DTU)

Korea Advanced Institute of Science and Technology(KAIST)

McMaster University

University of Amsterdam
Top Recommendations for You

DeepLearning.AI

HEC Paris

Duke University

University of Minnesota
Learn a New Skill in 2 Hours

Coursera
New on Coursera

Duke University





